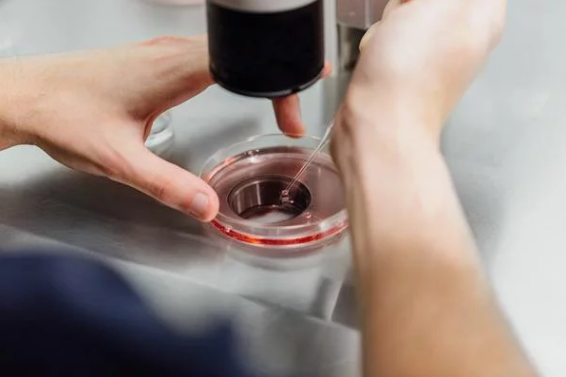
The woman opted for IVF treatments but failed. | Source: Pxhere

Infertility issues and how you can discuss them openly
)
Infertility in your 30s
Infertility struggles are painful, and resorting to IVF is a step that is financially and emotionally draining.
When one woman who had been trying for a baby for years without success discovered that her husband had been lying to her all along, she was understandably devastated.
The truth came out
It turns out he had a secret vasectomy before they got married. Now, the woman is so angry that she’s considering divorce.
“My husband, 50, had a secret vasectomy 10 years ago while he was married to his first wife. When we met 5 years ago he never disclosed this information and we got married 3 years ago,” she explained in a post on Reddit.
“We have been trying to have a baby, obviously without any luck until we opted to do IVF in Dec 2018 which was unsuccessful.”
“Last month I looked at all our tests results and it hit me that his zero sperm count several times on sperm analysis can’t be normal and suspected vasectomy.”
When she confronted her husband, he finally admitted he’d had a vasectomy but said he’d hoped it would “reverse itself naturally.”
The woman was devastated
“I feel very angry, betrayed and hurt that he allowed me to go through the emotional roller coaster of thinking I’m infertile and to even suggest IVF while he knew what the problem for us not falling pregnant was his vasectomy,” she wrote.
“It is difficult to trust him now. Should I stay or is should I divorce him and get someone who will be honest with me and who I know I’ll still have children with. I feel cheated and time is against me. I’m very conflicted on what to do.”
The post received more than 200 comments, with many people siding with the woman and saying that what her husband did was unforgivable.
Discussions on infertility and wanting to have kids should be openly discussed with your partner so that both can come to a mutual understanding and support each other on their decision.
Here’s how you can discuss infertility issues with your partner
- Avoid blame
It doesn’t matter who is infertile. After all, this is not something you have much control over. Reassure your partner that you’re in it together. Remember how you feel about your partner, why you love him or her, why you want to have a child together.
- Talk about it openly
Talk about your frustration and anger openly. Studies show that couples who keep their feelings hidden are much more likely to have problems related to the stress of infertility.
- Think of yourselves as a team
One of your first goals should be to understand the issue better together, so you may want to start your conversation by saying “I’m concerned and I think I we should discuss this with a doctor.” Consider some professional help to move the conversation forward.

- Get real about grief
Be honest about how you really feel and know that it’s OK to be sad. If either of you has a history of depression or anxiety, talk to each other about any changes in mood or behaviour that you notice in yourself or the other person. Try to avoid the negative self talk and shame about your bodies.
5. Keeping the relationship healthy
Consider taking a break from trying to get pregnant. Reducing the stress and anxiety in your sexual relationship now will ensure that your sex life will remain a source of pleasure and relaxation for years to come. Bring spontaneity back into sex and have sex dates that are not focused on reproducing.
SOURCE: Mayo Clinic
This article was first published on AfricaParent.com

![The truth about waist traners revealed [Credit: The Corset Center]](https://image.api.sportal365.com/process/smp-images-production/pulse.ng/13082024/663460ae-e4e0-4e3d-bfb5-364a61ff8afe?operations=autocrop(640:427))
![Here are 7 effective ways to control premature ejaculation [Credit: NetDoctor]](https://image.api.sportal365.com/process/smp-images-production/pulse.ng/13082024/f6fed057-1754-4a88-9ca5-6c13b67c0cfc?operations=autocrop(236:157))
![Here are 7 foods you need to eat for increased sexual stamina [Credit: Improving Men's Libido]](https://image.api.sportal365.com/process/smp-images-production/pulse.ng/13082024/4914d2bb-8cb1-4618-bf94-0b4b7731a10f?operations=autocrop(236:157))
![What are the causes of low sex drive in women and here’s how to increase it [Credit: Verywell Family]](https://image.api.sportal365.com/process/smp-images-production/pulse.ng/13082024/eb9deac7-dc68-4a01-8885-7317d43af034?operations=autocrop(236:157))
![Sperm- killers, here are 7 things that men need to watch out for [Credit: The Mary Sue]](https://image.api.sportal365.com/process/smp-images-production/pulse.ng/13082024/6b5ddea4-6aca-4b19-9cfd-730f94b6e876?operations=autocrop(236:157))
![7 common things that shouldn't be found in your bedroom. [bustle]](https://image.api.sportal365.com/process/smp-images-production/pulse.ng/31072024/f82f0b15-a166-4c63-bf98-c16ae77114f1?operations=autocrop(236:157))
)
)
![Here are 5 natural ways to combat erectile dysfunction [Credit: Video Blocks]](https://image.api.sportal365.com/process/smp-images-production/pulse.ng/13082024/5e3dc364-7318-40cb-a720-4ad5986ea32b?operations=autocrop(236:157))
)
)
)
)
)
)
)